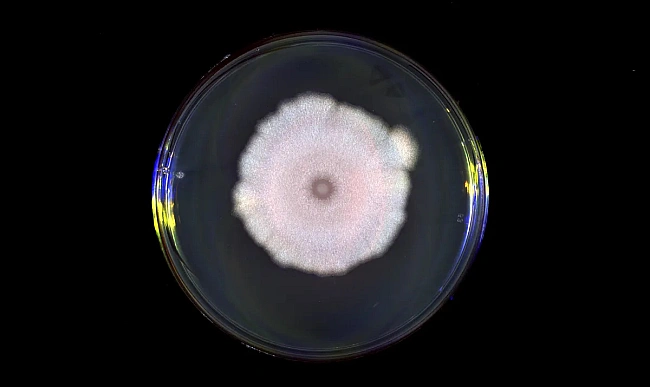

Не варто вірити усьому, що говорять: дезінформацію вперше використовували зовсім не люди (відео)
 Go to focus.ua
Go to focus.ua
Go to all channel news
Дослідники щойно виявили, що віруси насправді підслуховують розмови один одного, але часом вони також отримують неправдиву інформацію.
Go to focus.ua
Go to focus.ua
About news channel
-
Главные новости сегодня. Лента свежих новостей от онлайн журнала «ФОКУС» - актуальная аналитическая информация о последних событиях в Украине и мире.
All publications are taken from public RSS feeds in order to organize transitions for further reading of full news texts on the site.
Responsible: editorial office of the site focus.ua.